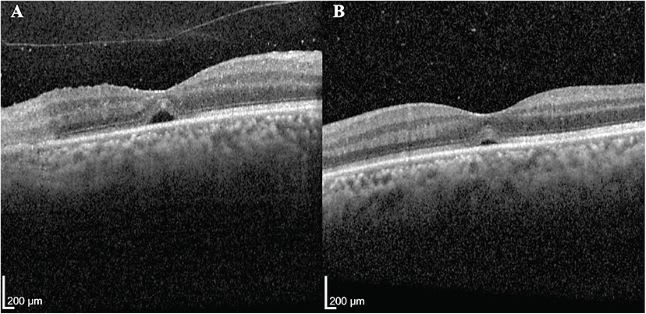
FIGURE 2. Ocular coherence tomography (OCT) images of macula of both eyes on initial presentation demonstrating (A) vitreous cells, full-thickness retinitis, and subfoveal fluid in the right eye and (B) vitreous cells and subfoveal fluid in the left eye. Images taken with Heidelberg Spectralis OCT system. IMAGES COURTESY VENKATKRISH M. KASETTY, MD; DHRUV SETHI, MD, MBA, MPH; AND EVGENY GELMAN, MD.

Cytomegalovirus (CMV) retinitis is a sight-threatening condition and a common ocular opportunistic infection seen in immunocompromised patients, such as those with acquired immune deficiency syndrome (AIDS).1,2 Vision loss in these patients usually occurs due to retinal necrosis, optic nerve atrophy, and retinal detachment (RD).3 RDs in CMV retinitis can either occur in the acute phase, with large retinal breaks in necrotic retina, or after the acute phase secondary to microbreaks from vitreoretinal gliosis and vitreous traction on inactive necrotic retina.4 Here, we present a case of bilateral CMV retinitis with a subsequent RD, along with a discussion of the medical and surgical considerations for these patients.
CASE PRESENTATION
A 52-year-old male with untreated HIV for 25 years presented with blurred vision in the right eye for several months. He had no fevers, chills, night sweats, weight loss, or other systemic symptoms. On initial examination, best-corrected visual acuity (BCVA) was 20/50 in the right eye and 20/25 in the left eye. Anterior segment examination of both eyes was significant for 1+ cell and inferior stellate KP. There were trace vitreous cells in both eyes. Dilated fundus exam revealed scattered intraretinal hemorrhages, vascular sheathing, and retinal whitening tracking along the vessels that was worse in the right eye. (Figure 1, A and B). Optical coherence tomography revealed vitreous cells, mild subretinal fluid (SRF), and full-thickness retinitis in both eyes (Figure 2). An anterior-chamber paracentesis was performed to test for CMV, varicella zoster virus (VZV), and herpes simplex virus (HSV). Intravitreal foscarnet sodium (Foscavir; Clinigen Healthcare) was then injected in both eyes. The patient was admitted for further workup and management of the HIV and retinitis. Further workup revealed an HIV load of 575,645 with a CD4+ count of 48. The AC tap was positive for CMV DNA. He was then started on oral valganciclovir, Bactrim (sulfamethoxazole/trimethoprim; Hoffmann-La Roche), and Biktarvy (bictegravir/emtricitabine/tenofovir; Gilead).

The patient received 6 intravitreal foscarnet injections over 3 weeks, which resulted in stabilization of the retinitis (Figure 1, C and D). However, 1 week after the sixth injection, the SRF worsened in the right eye (Figure 3A), which was suspected to be secondary to immune reconstitution uveitis (IRU). He was started on prednisolone eye drops 4 times daily in that eye. He returned 2 weeks later with worsening SRF in the right eye and his VA had decreased to 20/200 (Figure 3B). No retinal breaks were seen. Despite topical prednisolone and intravitreal foscarnet, his VA continued to worsen to light perception with worsening SRF (Figure 1, E and F; Figure 3C), which was now presumed to be from a RD from a temporal microbreak.

Approximately 2 months after initial presentation, the patient underwent pars plana vitrectomy (PPV) for surgical repair of the suspected RD. After a core vitrectomy was performed, the posterior hyaloid was stained with triamcinolone and shaved as much as possible as it was extremely adherent. An inferior tractional membrane was peeled and transected. Scleral depression did not reveal any breaks; however, a microbreak was suspected along the supratemporal edge of the detachment, given its configuration and progression pattern, and was marked with diathermy. Air-fluid exchange was performed and 5000 cs silicone oil was used to tamponade the detachment.
On postoperative day 1, the retina was attached and visual acuity had improved to hand motion. Prophylactic barrier laser was performed in the left eye. At last follow-up 4 months after PPV, the retina remained attached with a BCVA of 20/200 in the right eye and 20/60 in the left eye (Figure 1, G and H; Figure 3D).
DISCUSSION
Due to the presence of highly active antiretroviral therapy (HAART), the incidence of CMV retinitis is declining.5 It is an AIDS-defining illness but can occur in other immunocompromised populations.2 While CMV retinitis is a clinical diagnosis, it is important to keep a broad differential, including herpetic retinitis, syphilis, and tuberculosis—especially in immunocompromised individuals. Treatment of CMV retinitis includes HAART, oral/intravenous antivirals, and intravitreal foscarnet, ganciclovir, or cidofovir. Many studies have evaluated prognostic factors for CMV retinitis. Involvement of less than 50% of the retina is generally associated with better outcomes.6 Factors associated with poor visual outcomes in necrotizing viral retinitis include older age on presentation, poor initial visual acuity, worse vitritis, and an increased HIV viral load.7
As CMV retinitis is a full thickness retinal infection, it can lead to complications, including retinal necrosis with subsequent breaks and RDs, despite aggressive medical management. RDs are common complications in necrotizing viral retinitis, occurring in approximately 20% to 75% of eyes. They can occur more than a year after the initial infection.8,9 Factors associated with RD in these eyes include older age, impaired immune system, poor baseline visual acuity, worse vitritis, and receiving more than 5 intravitreal antiviral injections.7 Bavinger et al found a 1.2-fold increased risk of RD for every clock hour of retinitis, an important consideration for monitoring and counseling these patients on prognosis.9
Six weeks following the initial presentation, the patient developed SRF, which was initially attributed to IRU as the patient had recently started HAART therapy. IRU results in a transiently increased intraocular inflammation due to immune system reactivation in HIV patients after initiation of HAART therapy. Other complications of IRU include cataract and epiretinal membrane formation, glaucoma, and RD with proliferative vitreoretinopathy (PVR).10,11 Treatment for IRU includes topical, sub-Tenon, intravitreal, and oral corticosteroids. Intravitreal methotrexate has also been proposed for treatment of IRU.10 Eyes with IRU should be monitored closely due to an increased risk for RD.6
Despite topical prednisolone, the SRF continued to progress in a pattern suggestive of a RD originating from a temporal microbreak in the necrotic retina. In our case, the RD occurred 6 weeks after initial presentation despite stabilization of the retinitis. HAART therapy has been shown to reduce RD risk due to limiting retinitis progression as well as an increased inflammatory response from the reconstituted immune system, resulting in increased RPE-retina adhesion, and therefore compliance should be strongly encouraged in these patients.12
Detachments secondary to CMV retinitis are typically rhegmatogenous; however, multiple small posterior holes may develop.13 The optimal repair methods for CMV retinitis–associated RD involves PPV with silicone oil tamponade with possible scleral buckle. Vitrectomy using 20-gauge to 25-gauge instruments has demonstrated excellent anatomic outcomes, with reattachment rates between 63% and 94%.3
Despite reattachment, functional outcomes tend to be poor after RD repair, suggesting retinal atrophy as the major cause of poor vision.8,14 PVR and recurrent detachments requiring multiple surgeries are common.14 Kong et al found CD4+ counts <50 and a relaxed retinotomy were associated with recurrent RD.15 Therefore, the presence of long-term silicone oil may be optimal in these eyes to minimize chances of detachment, as retinal necrosis is usually the primary etiology of vision loss.
Prophylactic barrier laser and early vitrectomy have been explored to prevent RD in eyes with retinal necrosis. The role of both of these interventions is unclear.8,16-18 Sternberg et al demonstrated an increased likelihood of RD in eyes without prophylactic barrier laser; however, eyes without barrier laser had an opaque media limiting the view and likely portending a worse prognosis and inherent increased risk of RD.17,19 While studies on early vitrectomy to prevent RD have been inconclusive, the goal remains to remove vitreous traction and membranes, apply an intraocular tamponade, and provide an opportunity to perform barrier endolaser.16-18 We elected to perform prophylactic barrier laser in the left eye as the patient already had an RD in the right eye with poor vision potential.
CONCLUSION
CMV retinitis and its sequelae are challenging to manage and often lead to poor visual and anatomic outcomes. Appropriate medical and surgical management is necessary to optimize outcomes and should be managed with infectious disease colleagues. While the data are inconclusive, we recommend prophylactic barrier laser in cases such as ours to prevent an RD in the fellow eye. NRP
REFERENCES
- Jabs DA, Van Natta ML, Holbrook JT, Kempen JH, Meinert CL, Davis MD. Longitudinal study of the ocular complications of AIDS: ocular diagnoses at enrollment. Ophthalmology. 2007;114(4):780-786. doi:10.1016/j.ophtha.2006.11.008
- Iu LP, Fan MC, Lau JK, Chan TS, Kwong YL, Wong IY. Long-term follow-up of cytomegalovirus retinitis in non-HIV immunocompromised patients: clinical features and visual prognosis. Am J Ophthalmol. 2016;165:145-153. doi:10.1016/j.ajo.2016.03.015
- Moharana B, Dogra M, Tigari B, et al. Outcomes of 25-gauge pars plana vitrectomy for cytomegalovirus retinitis–related retinal detachment. Indian J Ophthalmol. 2021;69(9):2361-2366. doi:10.4103/ijo.IJO_3539_20
- Brar M, Kozak I, Freeman WR, Oster SF, Mojana F, Yuson RM. Vitreoretinal interface abnormalities in healed cytomegalovirus retinitis. Retina. 2010;30(8):1262-1266. doi:10.1097/IAE.0b013e3181cea6c1
- Sugar EA, Jabs DA, Ahuja A, Thorne JE, Danis RP, Meinert CL. Incidence of cytomegalovirus retinitis in the era of highly active antiretroviral therapy. Am J Ophthalmol. 2012;153(6):1016-1024.e5. doi:10.1016/j.ajo.2011.11.014
- Wong JX, Wong EP, Teoh SC. Outcomes of cytomegalovirus retinitis-related retinal detachment surgery in acquired immunodeficiency syndrome patients in an Asian population. BMC Ophthalmology. 2014;14(1):150. doi:10.1186/1471-2415-14-150
- Fitoussi L, Baptiste A, Mainguy A, et al. Clinical and virological characteristics and prognostic factors in viral necrotizing retinitis. J Pers Med. 2022;12(11):1785. doi:10.3390/jpm12111785
- Almeida DR, Chin EK, Tarantola RM, et al. Long-term outcomes in patients undergoing vitrectomy for retinal detachment due to viral retinitis. Clin Ophthalmol. 2015;9:1307-1314. doi:10.2147/opth.S87644
- Bavinger JC, Anthony CL, Lindeke-Myers AT, et al. Risk factors for retinal detachment in acute retinal necrosis. Ophthalmol Retina. 2022;6(6):478-483. doi:10.1016/j.oret.2022.01.016
- Urban B, Bakunowicz-Łazarczyk A, Michalczuk M. Immune recovery uveitis: pathogenesis, clinical symptoms, and treatment. Mediators Inflamm. 2014;2014:971417. doi:10.1155/2014/971417
- Yeo TH, Yeo TK, Wong EP, Agrawal R, Teoh SC. Immune recovery uveitis in HIV patients with cytomegalovirus retinitis in the era of HAART therapy—a 5-year study from Singapore. J Ophthalmic Inflamm Infect. 2016;6(1):41. doi:10.1186/s12348-016-0110-3
- Kempen JH, Jabs DA, Dunn JP, West SK, Tonascia J. Retinal detachment risk in cytomegalovirus retinitis related to the acquired immunodeficiency syndrome. Arch Ophthalmol. 2001;119(1):33-40. doi:10-1001/pubs.Ophthalmol.-ISSN-0003-9950-119-1-ecs90308
- Chuang EL, Davis JL. Management of retinal detachment associated with CMV retinitis in AIDS patients. Eye (Lond). 1992;6(Pt 1):28-34. doi:10.1038/eye.1992.4
- Wu CY, Fan J, Davis JL, et al. Surgical outcomes of acute retinal necrosis–related retinal detachment in polymerase chain reaction–positive patients: a single-center experience. Ophthalmol Retina. 2022;6(11):992-1000. doi:10.1016/j.oret.2022.05.023
- Kong W, Tao Y, Xie L, Du K, Dong H, Wei W. Prognostic factors for outcome after vitrectomy for retinal detachment secondary to cytomegalovirus retinitis in patients with AIDS: a retrospective single-center analysis. Ocul Immunol Inflamm. 2021;29(7-8):1547-1552. doi:10.1080/09273948.2020.1764591
- Risseeuw S, de Boer JH, Ten Dam-van Loon NH, van Leeuwen R. Risk of rhegmatogenous retinal detachment in acute retinal necrosis with and without prophylactic intervention. Am J Ophthalmol. 2019;206:140-148. doi:10.1016/j.ajo.2019.05.023
- Schoenberger SD, Kim SJ, Thorne JE, et al. Diagnosis and treatment of acute retinal necrosis: a report by the American Academy of Ophthalmology. Ophthalmology. 2017;124(3):382-392. doi:10.1016/j.ophtha.2016.11.007
- Shantha JG, Weissman HM, Debiec MR, Albini TA, Yeh S. Advances in the management of acute retinal necrosis. Int Ophthalmol Clin. 2015;55(3):1-13. doi:10.1097/iio.0000000000000077
- Sternberg P, Han DP, Yeo JH, et al. Photocoagulation to prevent retinal detachment in acute retinal necrosis. Ophthalmology. 1988;95(10):1389-1393. doi:https://doi.org/10.1016/S0161-6420(88)32999-4








